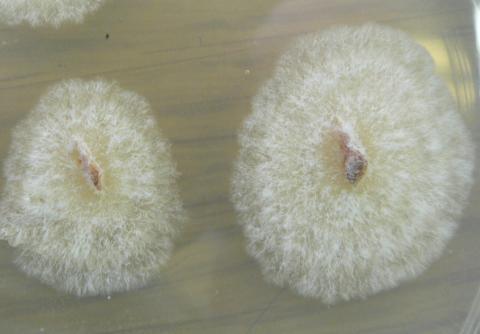
Dutch elm disease fungus growing in a Petri dish.

Hosts
Only elms (Ulmus species) and closely related plants (Planera) are susceptible to the Dutch elm disease fungus. American elm (U. americana) is very susceptible. Lacebark or Chinese elm (U. parvifolia) and the Siberian elm (U. pumila) are the most resistant species, but natural infections of these species and their hybrids sometimes do occur.